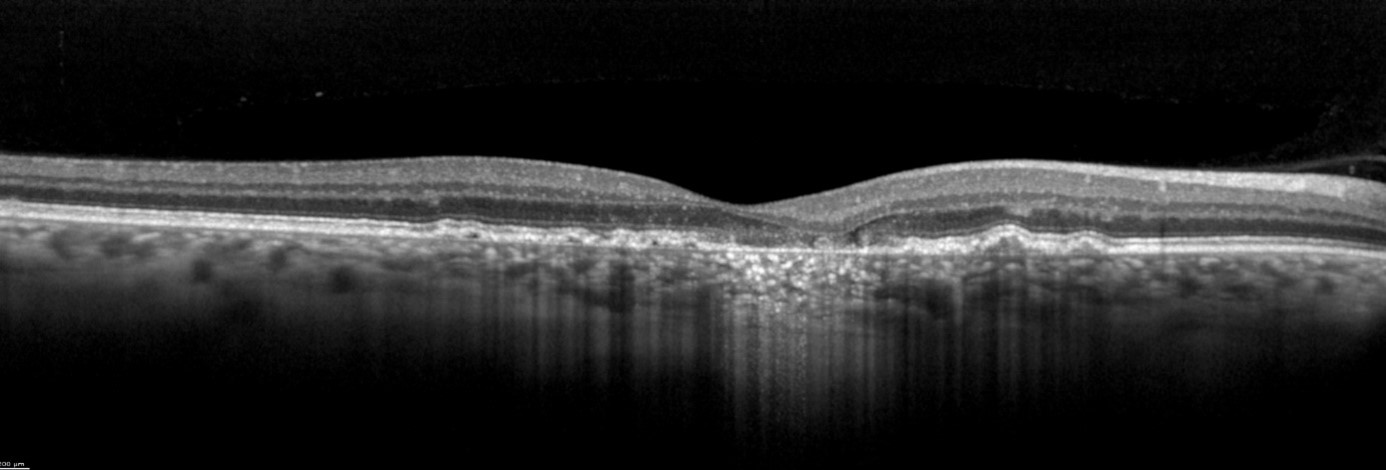

The U.S. Food and Drug Administration (FDA) has approved a drug for the treatment of geographic atrophy (GA) for the first time, one of the advanced forms of dry age-related macular degeneration (AMD). The approval is considered a breakthrough in ophthalmology and finally gives patients hope of positively impacting the course of the disease.

The U.S. Food and Drug Administration (FDA) has approved a drug for the treatment of geographic atrophy (GA) for the first time, one of the advanced forms of dry age-related macular degeneration (AMD). The approval is considered a breakthrough in ophthalmology and finally gives patients hope of positively impacting the course of the disease.
With the announcement of new treatments for GA, the importance of multimodality imaging, particularly to rule out neovascular AMD or diseases that manifest similarly to dry AMD, is once again resurging. SPECTRALIS® combines high-resolution OCT images with various detailed fundus imaging modalities such as Blue Autofluorescence, Infrared or MultiColor on one platform.
BluePeak imaging can serve as a surrogate marker for retinal pigment epithelium (RPE) and photoreceptor pathology, and in this way supports the assessment of various retinal diseases such as AMD or genetic diseases. Non-invasive blue autofluorescence can show a stronger contrast between atrophic and healthy retina compared to fundus photography images in geographic atrophy. Using RegionFinder software, the areas of reduced autofluorescence visible in the BluePeak image can be reliably quantified and documented as they progress. BluePeak with RegionFinder enables quantitative RPE checks for reliable support in disease monitoring. In a comparative study, fundus autofluorescence images obtained with SPECTRALIS confocal scanning laser ophthalmoscopy (cSLO) performed very well compared to other cSLO systems. In particular, the image brightness and low background noise allowed for more contrast and better gray shading.

Image 1: Monitoring of GA using BluePeak in combination with RegionFinder software
The vitality of the RPE is not the only factor of importance in GA. One of the advantages of OCT imaging is the three-dimensional cross-sectional imaging, which allows detailed viewing of fine structures. Individual retinal layers can be visualized to assess the RPE and photoreceptors. OCT is also a useful method to examine areas surrounding atrophy, such as discontinuous outer bands (external limiting membrane, ellipsoid zone, and RPE, as well as "outer retinal tubulations" (ORT)). In addition to fundoscopy and fluorescein angiography, high-resolution SD-OCT should primarily be used for diagnosis and follow-up of active choroidal neovascularization (CNV). according to professional associations.
Image 2: SPECTRALIS high-resolution OCT image courtesy of Dr. Rosa Dolz-Marco, Valencia, Spain
The transverse section or en-face OCT image option provides a unique visualization of RPE and photoreceptor structure, adding complementary information relating to the distribution of pathological change within the posterior segment. One characteristic of GA is choroidal hypertransmission defects, a “window” defect through the RPE associated with nascent GA (nGA) and cRORA, providing a complementary alternative to autofluorescence images.

Image 3: Transverse section OCT – choroidal hypertransmission defect recorded with SPECTRALIS
Heidelberg Engineering's patented TruTrack Active Eye Tracking technology for SPECTRALIS enables highly effective noise reduction and precisely reproducible scan (re-)positioning, which are key to more accurate diagnosis and reliable monitoring of the progression of retinal diseases such as AMD. Throughout the image acquisition process, eye movement is detected in real time and the acquiring OCT beam is positioned accordingly. Impressive OCT images are produced, even with frequent eye movement or blinking. TruTrack lays the foundation for precise, automated follow-up scans and dynamic visualization of pathology using colocalized cSLO and OCT images. This helps physicians in their daily routine to work more efficiently and examine and monitor patients thoroughly, even in difficult cases that show very small changes over time.
By using three simultaneous laser wavelengths with different penetration depths, MultiColor can provide valuable image data about the nature of the retinal layers. This allows visualization of structures and pathologic changes that are not always clearly visible with conventional fundus photography. The monochromatic images provide contrast of GA boundaries similar to fundus autofluorescence. A scientific article by Steffen Schmitz-Valckenberg et al. demonstrates the high reliability of MultiColor for the assessment of GA. There is "very high inter- and intragrader agreement in the assessment of GA area and width (ICC > 0.99 and ICC 0.92-0.973, respectively). MultiColor also provided better contrast than CFP, FAF, and NIR-FAF for GA borders and foveal recess."

Image 4: Fundus Camera image (left) in comparison to MultiColor (right) in GA
OCT Angiography (OCTA) – Detailed imaging of fine capillary vessels
The non-invasive SPECTRALIS OCT angiography module provides high-resolution OCTA images with a lateral resolution of up to 5.7 μm per pixel. Combined with the precision of TruTrack Active Eye Tracking, this enables detailed imaging of fine capillary vessels. An advantage of OCT angiography for the diagnosis of AMD is the ability to visualize the presence or absence of choroidal capillaries. This may aid in the differential diagnosis of GA and atrophy due to other diseases.
HEYEX 2 – Solution for image data management and device integration
Heidelberg Eye Explorer HEYEX 2 enables optimal management of images and other patient data – it supports a comprehensive diagnosis on a single platform. Despite the growing volume of information, you do not lose the overview. The platform enables convenient access to the multimodal images of all Heidelberg Engineering devices and interfaces to third-party systems.
HEYEX 2 with Heidelberg AppWay, enable physicians to access third party ophthalmic “apps” that provide additional diagnostic insight. The cloud technology-based "gateway solution" offers a secure workflow that leverages the strengths of Heidelberg Engineering image quality with innovative deep learning algorithms. Users can send images from any Heidelberg Engineering device to artificial intelligence analytics providers such as RetInSight or RetinAI to perform a detailed analysis of the scans obtained. This can provide new diagnostic information or additional decision support. Heidelberg Engineering is also working on expanding its range of ophthalmic apps through cooperation with other analytics providers steadily.
Powerful imaging modalities on one platform
The combination of blue autofluorescence, infrared, high-resolution OCT imaging and other imaging modalities such as MultiColor and OCTA on one platform makes the SPECTRALIS an optimal tool for diagnostics and follow-up of AMD. The preserved core technologies of the SPECTRALIS (Active Eye Tracking and AutoRescan) support the precise tracking of the disease over time.
[1] Bellmann C, et al: “Fundus autofluorescence imaging compared with different confocal scanning laser ophthalmoscopes”. Br J Ophthalmol. 2003; 87(11):1381-6.
[2] Schmitz-Valckenberg, S, et al.: „Geographische Atrophie: Differentialdiagnose, Verlauf und aktuelle Therapieansätze“, Z. prakt. Augenheilkd. 35: 275–286 (2014).